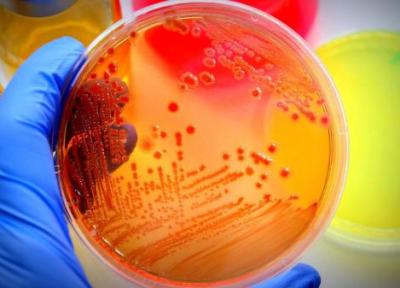

آخرین ارسال ها در وبلاگ های سهندبلاگ | صفحه 66

قیمت های عجیب سگ قهدریجانی
سگ قهدریجانی که از جمله سگ های نژاد دار ایرانی است، به عنوان محافظ و نگهبان گله شناخته می گردد. سگی که کمتر چوبان و دامداری حاضر است، آن را از دست بدهد. شاید به همین علت است که بازار خرید و فروش این نوع از سگ در پلتفرم های خرید و فروش آنلاین داغ شده است.

در ساحل به بارسلونا می رود
فیلم کوتاه در ساحل به تهیه کنندگی، نویسندگی و کارگردانی ابوالحسن کیوان برای حضور در بخش اصلی جشنواره عشق و امید بارسلونا پذیرفته شد.

برترین مودم های فیبر نوری فایبرهوم بازار ایران
اگر قصد خرید یک مودم فیبر نوری داشته باشید؛ احتمالا یکی از مودم های هواوی یا فایبرهوم به شما معرفی گردد.

پاستا آشیانه ای با مرغ و قارچ
پاستاها جزو غذاهایی هستند که بین بچه ها و بزرگ ترها هواداران ویژه ای دارند و معمولا دستورهای پخت متفاوت و خوشمزه ای دارند.

آیا مصرف کم نمک واقعاً برای سلامتی مفید است؟
حتما بسیاری از شما شنیده اید که رژیم های غذایی کم نمک برای حفظ سلامتی ما و به ویژه افرادی که با بیماری های قلبی و عروقی درگیر هستند، بسیار لازم است، اما یافته های شگفت انگیز یک مطالعه تازه علمی اخیراً نشان می دهد که رژیم غذایی کم نمک از مرگ یا مراجعه به...

می دانید صنایع دستی شیراز چقدر متنوع است؟
شیراز شهری زیبا است که سالانه افراد زیادی به آن سفر می نمایند. این شهر جاذبه های گردشگری متنوعی مانند امامزاده شاه چراغ، حافظیه، سعدیه، تخت جمشید، مقبره کوروش، آرامگاه شاه شجاع، آرامگاه خواجوی کرمانی، باغ هفتنان، موزه کاشی و سنگ، بازار و مسجد وکیل و…...

خواص بی نظیر عدس که همه باید بدانند!
عدس برای سلامتی بسیار مفید است. عدس سرشار از پروتئین گیاهی، پتاسیم، فیبر، ویتامین ها و مواد معدنی نظیر ویتامین B9 و اسید فولیک است.

موزه های تهران تعطیل شد
سرپرست اداره کل موزه ها از تعطیلی موزه های استان تهران در روز سه شنبه 27 اردیبهشت ماه به علت آلودگی هوا خبر داد.

شرایط حضور علویان در اردبیل فراهم می گردد
ایرنا/ براساس آخرین خبر و گزارش های منتشر شده، شرایط حضور علویان در اردبیل فراهم می گردد.

قیمت کارخانه ای خودرو دوباره تغییر کرد؟
به گزارش خبرنگاران، به نقل از مهر، منوچهر منطقی در پاسخ به این سوال که طبق مصوبات قبلی، قیمت خودرو هر 6 ماه یک بار باید تغییر کند و به همین علت، خرداد ماه موعد تغییر قیمت خودرو است، آیا وزارت صمت برنامه ای برای تغییر قیمت دارد یا خیر، اظهار کرد: هنوز هیچ...

عایدی هنگفت سرالکس فرگوسن در 80 سالگی
به گزارش سان، فرگوسن در سال 2013 پس از کسب 13 عنوان قهرمانی لیگ برتر و دو جام لیگ قهرمانان اروپا اعلام بازنشستگی کرد. به گزارش سان، فرگوسن 9 سال پس از گذراندن دوران 26 ساله خود در اولدترافورد سالانه دو میلیون پوند به عنوان سفیر منچستریونایتد عایدی دارد. این...

مشخص حریم شهر تاریخی سیمره انجام می شود
میراث آریا/ براساس آخرین گزارش های منتشر شده و خبرهای بدست رسیده، معین حریم شهر تاریخی سیمره انجام می شود.

8 خاصیت گیاهخواری
متخصصان تغذیه می گویند با پیروی از رژیم غذایی گیاهخواری، تجمع پلاک در رگ های خونی کاهش می یابد و خطر ابتلا به دیابت و سکته مغزی کم می شود و اگر حق انتخاب داشته باشیم، رژیم گیاهخواری از دیگر رژیم ها بهتر به نظر می رسد.

خرید41 مدل چراغ سیار با جنس بسیار عالی وقیمت مناسب
با کشف الکتریسیته ، انواع چراغ ها در زندگی ، ویژگی های کاربری متنوعی را ارائه می دهند. لامپ های روشنایی با ویژگی های مختلف طراحی و به وسیله برندهای خاصی برای فروش عرضه می شوند. چراغ سیار از پرطرفدارترین این محصولات بوده که در ادامه به معرفی و کاریرد آن...

والت دیزنی؛ آنکه موسیقی کلاسیک را به سینما هدیه کرد
نخستین تجربه والت دیزنی در ساخت انیمشن های موزیکال، با مجموعه انیمیشن های سمفونی احمقانه شکل گرفت؛ انیمشن های کوتاه و 75 قسمتی که بین سال های 1929 تا 1939 در طول یک دهه عرضه شد و پیروز به کسب 7 جایزه اسکار شد.

کشف یک تکه پازل نو از معمای حیات در مریخ!
مریخ دهه هاست که به عنوان جدی ترین امید بشر برای توسعه حیات در آن شناخته می شود و به همین دلیل تلاش های بسیاری اجرا شده تا تاریخچه وجود حیات احتمالی در آن شناخته شود. در یک دستاورد نو علمی، یک تیم تحقیقاتی به رهبری دانشگاه لوند در سوئد شهاب سنگی از مریخ...

خدمات تولید محتوا اینستاگرام برای رستوران هاخدمات تولید محتوا اینستاگرام برای رستوران ها
خدمات تولید محتوا اینستاگرام برای رستوران هارستوران ها یکی از کسب و کارهایی هستند که برای جذب و نگهداری مشتری در اینترنت، به شدت به اینستاگرام نیاز دارند. حال اگر این اتفاق به درستی بیافتد منجر به افزایش جلب مخاطبین در رسانه اینستاگرام شده و برای رستوران...
طراحی نانوکارخانه برای یاری به ساخت دارو و مواد شیمیایی
با استفاده از پتانسیل های موجود در حوزه میکروبیولوژی، محققان دانشگاه ایالتی میشیگان راستا تازه ای باز کردند که می تواند منجر به ساخت داروها، ویتامین ها و موارد دیگر با هزینه کمتر و با کارایی بهتر گردد.

نمایشگاه E3 2022 رسما لغو شد؛ نه حضوری و نه دیجیتال
کمپانی ESA (برگزار کننده نمایشگاه E3) در بیانیه ای عجیب به تازگی اعلام نموده که مراسم E3 امسال به طور کامل لغو شده است. این رویداد قرار بود تابستان امسال به صورت دیجیتالی و آنلاین برگزار گردد اما به نظر می رسد که دیگر خبری از آن در سال 2022 نخواهد بود.

بهبود رتبه منطقه 14 در حوزه عملکردی و درآمدی
خبرگزاری خبرنگاران-گزارش شرایط شاخص درآمد ،عملیات اجرایی و پروژه های منطقه 14 حاکی از تحول و پیشرفت رتبه و رویکرد منطقه طی 5 ماه اخیر نسبت به ماه های ابتدایی سال 1400 است.